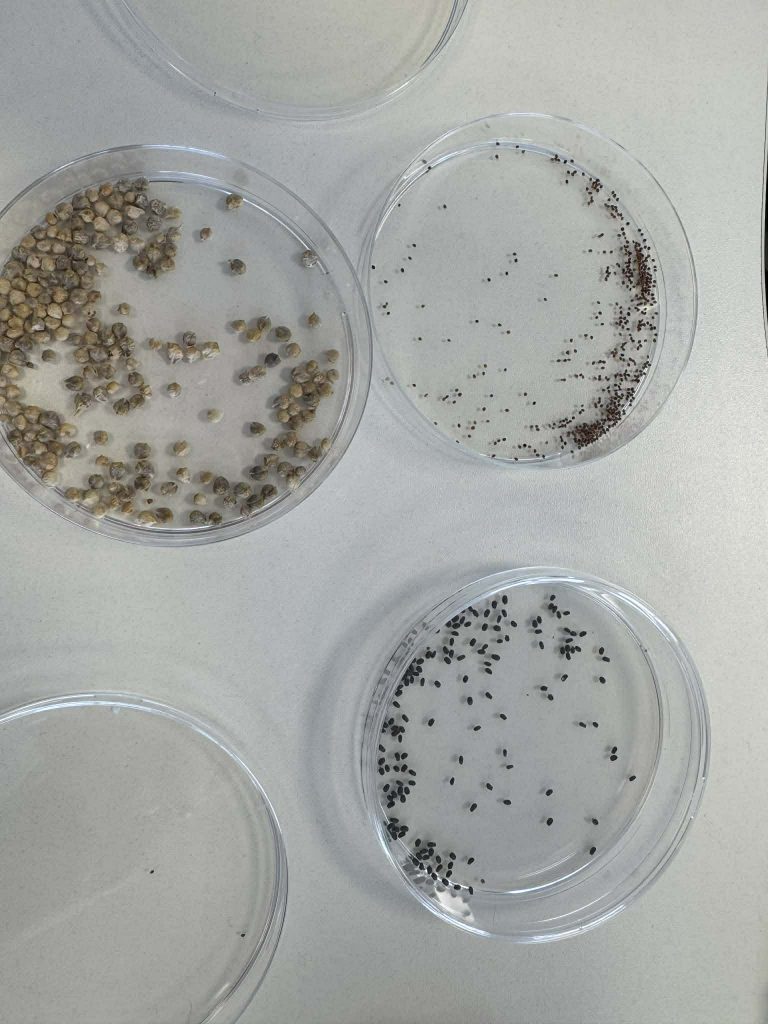

Onuškio Donato Malinausko pagrindinės mokyklos 2–3 klasių mokiniai balandžio 23 dieną lankėsi Onuškio bibliotekoje, kur jų laukė itin įdomi ir įtraukianti edukacija su knygos „Gmopolis“ autore, rašytoja ir biologe Urte Starkevič.
Susitikimo metu viešnia ne tik papasakojo apie savo knygos gimimo istoriją ir kūrybinį procesą, bet ir pakvietė vaikus tapti tikrais mokslo tyrinėtojais. Mokiniai aktyviai dalyvavo praktiniuose eksperimentuose: susipažino su laboratoriniais įrankiais, sužinojo, kaip auginamos bakterijos, ir netgi patys išbandė bakterijos „infiltravimo“ į augalą procesą.
Tokie susitikimai skatina mokinių smalsumą, padeda pamatyti, kaip teorinės žinios virsta realiais atradimais, ir įrodo, kad mokslas gali būti ne tik naudingas, bet ir be galo įdomus. Dėkojame Onuškio bibliotekai ir Urtei Starkevič už suteiktas žinias ir įkvepiantį pavyzdį!